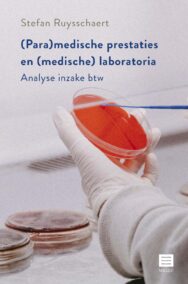
(Para)medische prestaties en (medische) laboratoria. Analyse inzake btw

Kasstroomanalyse en financiële bedrijfsanalyse – Management accounting technieken ten behoeve van de accountant van kleine vennootschappen. (Bijzondere reeks BBB, nr. 1)
€ 39,00
Bijzondere reeks Beroepsvereniging voor Boekhoudkundige Beroepen (BBB), nr. 1
Naast het uitvoeren van voornamelijk boekhoudkundige en fiscale taken, moet een accountant vandaag ook meer en meer onderlegd zijn in bedrijfskundige materies. Inderdaad, zijn klanten verwachten dat hij in staat is om het ondernemingssturen in steeds belangrijker mate mee vorm te geven. Met andere woorden, deze ontwikkeling vereist van de accountant een degelijke scholing in management accounting.
In het kader van deze uitbreiding van accountantsactiviteiten, brengen wij in dit werk dan ook een tweetal fundamentele management accounting technieken onder de aandacht: kasstroomanalyse en financiële bedrijfsanalyse.
Kasstroomcalculatietools laten de accountant toe zijn klanten te adviseren in verband met financiële beleidsbeslissingen die van invloed zijn op de waarde van hun onderneming.
Financiële bedrijfsanalyse betreft een aantal analysetechnieken die de accountant kan gebruiken, om informatie in de jaarrekeningen van zijn klanten te converteren in indicatoren die een duidelijk beeld geven van de financiële prestaties van hun onderneming.
Met deze publicatie menen we een bijdrage te hebben geleverd om het fundamenteel belang van de kennis van management accounting, met betrekking tot de bedrijfsadviesfunctie van de accountant, in de verf te zetten.
Dr. Jacques Van Der Elst is doctor in business administration (Newport University CA, state approved, 1994), master in financieel management, master in accountancy, gediplomeerde in de boekhoudkundige expertise en gegradueerde in de boekhouding.
Hij bekleedde meerdere financiële directiefuncties in grote bedrijven en was als accountant gerechtsdeskundige bij diverse Rechtbanken van Koophandel.
J. Van Der Elst doceerde zowel op academisch als hogeschoolniveau en gaf vakken zoals statistiek, financiële wiskunde, financieel management, financiële analyse, beleggingsleer, bedrijfseconomie en cost accounting.
De auteur was ook lid van het Instituut van de Accountants en Belastingconsulenten (IAB). Meer dan 20 jaar is hij bij het IAB jurylid geweest van de eindexamencommissies.
Zijn vele publicaties situeren zich in de domeinen van de toegepaste wiskunde, het financieel management, de bedrijfseconomie en de accountancy.
Naast het uitvoeren van voornamelijk boekhoudkundige en fiscale taken, moet een accountant vandaag ook meer en meer onderlegd zijn in bedrijfskundige materies. Inderdaad, zijn klanten verwachten dat hij in staat is om het ondernemingssturen in steeds belangrijker mate mee vorm te geven. Met andere woorden, deze ontwikkeling vereist van de accountant een degelijke scholing in management accounting.
In het kader van deze uitbreiding van accountantsactiviteiten, brengen wij in dit werk dan ook een tweetal fundamentele management accounting technieken onder de aandacht: kasstroomanalyse en financiële bedrijfsanalyse.
Kasstroomcalculatietools laten de accountant toe zijn klanten te adviseren in verband met financiële beleidsbeslissingen die van invloed zijn op de waarde van hun onderneming.
Financiële bedrijfsanalyse betreft een aantal analysetechnieken die de accountant kan gebruiken, om informatie in de jaarrekeningen van zijn klanten te converteren in indicatoren die een duidelijk beeld geven van de financiële prestaties van hun onderneming.
Met deze publicatie menen we een bijdrage te hebben geleverd om het fundamenteel belang van de kennis van management accounting, met betrekking tot de bedrijfsadviesfunctie van de accountant, in de verf te zetten.
Dr. Jacques Van Der Elst is doctor in business administration (Newport University CA, state approved, 1994), master in financieel management, master in accountancy, gediplomeerde in de boekhoudkundige expertise en gegradueerde in de boekhouding.
Hij bekleedde meerdere financiële directiefuncties in grote bedrijven en was als accountant gerechtsdeskundige bij diverse Rechtbanken van Koophandel.
J. Van Der Elst doceerde zowel op academisch als hogeschoolniveau en gaf vakken zoals statistiek, financiële wiskunde, financieel management, financiële analyse, beleggingsleer, bedrijfseconomie en cost accounting.
De auteur was ook lid van het Instituut van de Accountants en Belastingconsulenten (IAB). Meer dan 20 jaar is hij bij het IAB jurylid geweest van de eindexamencommissies.
Zijn vele publicaties situeren zich in de domeinen van de toegepaste wiskunde, het financieel management, de bedrijfseconomie en de accountancy.
Kasstroomanalyse en financiële bedrijfsanalyse – Management accounting technieken ten behoeve van de accountant van kleine vennootschappen. (Bijzondere reeks BBB, nr. 1)
€ 39,00
Bijzondere reeks Beroepsvereniging voor Boekhoudkundige Beroepen (BBB), nr. 1
Naast het uitvoeren van voornamelijk boekhoudkundige en fiscale taken, moet een accountant vandaag ook meer en meer onderlegd zijn in bedrijfskundige materies. Inderdaad, zijn klanten verwachten dat hij in staat is om het ondernemingssturen in steeds belangrijker mate mee vorm te geven. Met andere woorden, deze ontwikkeling vereist van de accountant een degelijke scholing in management accounting.
In het kader van deze uitbreiding van accountantsactiviteiten, brengen wij in dit werk dan ook een tweetal fundamentele management accounting technieken onder de aandacht: kasstroomanalyse en financiële bedrijfsanalyse.
Kasstroomcalculatietools laten de accountant toe zijn klanten te adviseren in verband met financiële beleidsbeslissingen die van invloed zijn op de waarde van hun onderneming.
Financiële bedrijfsanalyse betreft een aantal analysetechnieken die de accountant kan gebruiken, om informatie in de jaarrekeningen van zijn klanten te converteren in indicatoren die een duidelijk beeld geven van de financiële prestaties van hun onderneming.
Met deze publicatie menen we een bijdrage te hebben geleverd om het fundamenteel belang van de kennis van management accounting, met betrekking tot de bedrijfsadviesfunctie van de accountant, in de verf te zetten.
Dr. Jacques Van Der Elst is doctor in business administration (Newport University CA, state approved, 1994), master in financieel management, master in accountancy, gediplomeerde in de boekhoudkundige expertise en gegradueerde in de boekhouding.
Hij bekleedde meerdere financiële directiefuncties in grote bedrijven en was als accountant gerechtsdeskundige bij diverse Rechtbanken van Koophandel.
J. Van Der Elst doceerde zowel op academisch als hogeschoolniveau en gaf vakken zoals statistiek, financiële wiskunde, financieel management, financiële analyse, beleggingsleer, bedrijfseconomie en cost accounting.
De auteur was ook lid van het Instituut van de Accountants en Belastingconsulenten (IAB). Meer dan 20 jaar is hij bij het IAB jurylid geweest van de eindexamencommissies.
Zijn vele publicaties situeren zich in de domeinen van de toegepaste wiskunde, het financieel management, de bedrijfseconomie en de accountancy.
Naast het uitvoeren van voornamelijk boekhoudkundige en fiscale taken, moet een accountant vandaag ook meer en meer onderlegd zijn in bedrijfskundige materies. Inderdaad, zijn klanten verwachten dat hij in staat is om het ondernemingssturen in steeds belangrijker mate mee vorm te geven. Met andere woorden, deze ontwikkeling vereist van de accountant een degelijke scholing in management accounting.
In het kader van deze uitbreiding van accountantsactiviteiten, brengen wij in dit werk dan ook een tweetal fundamentele management accounting technieken onder de aandacht: kasstroomanalyse en financiële bedrijfsanalyse.
Kasstroomcalculatietools laten de accountant toe zijn klanten te adviseren in verband met financiële beleidsbeslissingen die van invloed zijn op de waarde van hun onderneming.
Financiële bedrijfsanalyse betreft een aantal analysetechnieken die de accountant kan gebruiken, om informatie in de jaarrekeningen van zijn klanten te converteren in indicatoren die een duidelijk beeld geven van de financiële prestaties van hun onderneming.
Met deze publicatie menen we een bijdrage te hebben geleverd om het fundamenteel belang van de kennis van management accounting, met betrekking tot de bedrijfsadviesfunctie van de accountant, in de verf te zetten.
Dr. Jacques Van Der Elst is doctor in business administration (Newport University CA, state approved, 1994), master in financieel management, master in accountancy, gediplomeerde in de boekhoudkundige expertise en gegradueerde in de boekhouding.
Hij bekleedde meerdere financiële directiefuncties in grote bedrijven en was als accountant gerechtsdeskundige bij diverse Rechtbanken van Koophandel.
J. Van Der Elst doceerde zowel op academisch als hogeschoolniveau en gaf vakken zoals statistiek, financiële wiskunde, financieel management, financiële analyse, beleggingsleer, bedrijfseconomie en cost accounting.
De auteur was ook lid van het Instituut van de Accountants en Belastingconsulenten (IAB). Meer dan 20 jaar is hij bij het IAB jurylid geweest van de eindexamencommissies.
Zijn vele publicaties situeren zich in de domeinen van de toegepaste wiskunde, het financieel management, de bedrijfseconomie en de accountancy.
KleuterKracht. Een praktijkboek voor meer stem, keuze en eigenaarschap bij peuters en kleuters
€ 23,50
KleuterKracht! Een boek met maar liefst achttien interactie- en werkvormen die je op weg zetten om de stem, keuze en het eigenaarschap van jonge kinderen een plaats te geven binnen de verbondenheid van de groep. Ze zetten in op ‘agency’ binnen je dagdagelijkse klaswerking met peuters en kleuters.
Elke werkvorm is uitgeschreven als een stappenplan met een uitgesproken rol voor de kinderen om ideeën en inhoud aan te brengen, terwijl de structuur in de handen van de leerkracht ligt. Op die manier houd je als (aankomende) leerkracht het overzicht, terwijl er toch erg veel ruimte is voor de interesses en inbreng van de kinderen.
Inzetten op agency biedt heel wat ontwikkelingskansen bij jonge kinderen. Het heeft een positieve invloed op hun motivatie, zelfwaarde, probleemoplossende vaardigheden en nog veel meer. Het helpt hen op weg om op te komen voor wat ze belangrijk vinden, voor zichzelf, maar ook voor anderen, nu en ook later. Tegelijk biedt het jou als leerkracht ook kansen om de kinderen in je klas nog beter te leren kennen, om zo te kunnen inspelen en verder bouwen op wat bij hen leeft.
In KleuterKracht vind je naast de agency-werkvormen ook een theoretische en didactische verantwoording die je in staat stelt om onderbouwde keuzes te maken in welke werkvormen je inzet en hoe je die aanpast naar je eigen context.
Elke werkvorm werd door peuter- en kleuteronderwijzers in de praktijk getest. Hun bevindingen en opmerkingen geven je een concreet en realistisch beeld van wat je mag verwachten wanneer je aan de slag gaat met dit boek.
KleuterKracht is het resultaat van onderzoek in het expertisecentrum Education & Development van UCLL Research & Expertise.
Anne Slaets is lector pedagogische wetenschappen, praktijkbegeleider en onderzoeker in de Hogeschool UCLL Bachelor Kleuteronderwijzer. Ze doet onderzoek naar specifieke thema’s rond het jonge kind zoals opvoedingsrelatie en agency.
Hilde Stroobants is onderzoeker, lector pedagogische wetenschappen, praktijkbegeleider en nascholingsdocent aan de Hogeschool UCLL. Haar focus in onderzoek ligt bij leer- en denkprocessen en bij het jonge kind. Ze geeft les in de Bachelor Kleuteronderwijzer.
Elke werkvorm is uitgeschreven als een stappenplan met een uitgesproken rol voor de kinderen om ideeën en inhoud aan te brengen, terwijl de structuur in de handen van de leerkracht ligt. Op die manier houd je als (aankomende) leerkracht het overzicht, terwijl er toch erg veel ruimte is voor de interesses en inbreng van de kinderen.
Inzetten op agency biedt heel wat ontwikkelingskansen bij jonge kinderen. Het heeft een positieve invloed op hun motivatie, zelfwaarde, probleemoplossende vaardigheden en nog veel meer. Het helpt hen op weg om op te komen voor wat ze belangrijk vinden, voor zichzelf, maar ook voor anderen, nu en ook later. Tegelijk biedt het jou als leerkracht ook kansen om de kinderen in je klas nog beter te leren kennen, om zo te kunnen inspelen en verder bouwen op wat bij hen leeft.
In KleuterKracht vind je naast de agency-werkvormen ook een theoretische en didactische verantwoording die je in staat stelt om onderbouwde keuzes te maken in welke werkvormen je inzet en hoe je die aanpast naar je eigen context.
Elke werkvorm werd door peuter- en kleuteronderwijzers in de praktijk getest. Hun bevindingen en opmerkingen geven je een concreet en realistisch beeld van wat je mag verwachten wanneer je aan de slag gaat met dit boek.
KleuterKracht is het resultaat van onderzoek in het expertisecentrum Education & Development van UCLL Research & Expertise.
Anne Slaets is lector pedagogische wetenschappen, praktijkbegeleider en onderzoeker in de Hogeschool UCLL Bachelor Kleuteronderwijzer. Ze doet onderzoek naar specifieke thema’s rond het jonge kind zoals opvoedingsrelatie en agency.
Hilde Stroobants is onderzoeker, lector pedagogische wetenschappen, praktijkbegeleider en nascholingsdocent aan de Hogeschool UCLL. Haar focus in onderzoek ligt bij leer- en denkprocessen en bij het jonge kind. Ze geeft les in de Bachelor Kleuteronderwijzer.
KleuterKracht. Een praktijkboek voor meer stem, keuze en eigenaarschap bij peuters en kleuters
€ 23,50
KleuterKracht! Een boek met maar liefst achttien interactie- en werkvormen die je op weg zetten om de stem, keuze en het eigenaarschap van jonge kinderen een plaats te geven binnen de verbondenheid van de groep. Ze zetten in op ‘agency’ binnen je dagdagelijkse klaswerking met peuters en kleuters.
Elke werkvorm is uitgeschreven als een stappenplan met een uitgesproken rol voor de kinderen om ideeën en inhoud aan te brengen, terwijl de structuur in de handen van de leerkracht ligt. Op die manier houd je als (aankomende) leerkracht het overzicht, terwijl er toch erg veel ruimte is voor de interesses en inbreng van de kinderen.
Inzetten op agency biedt heel wat ontwikkelingskansen bij jonge kinderen. Het heeft een positieve invloed op hun motivatie, zelfwaarde, probleemoplossende vaardigheden en nog veel meer. Het helpt hen op weg om op te komen voor wat ze belangrijk vinden, voor zichzelf, maar ook voor anderen, nu en ook later. Tegelijk biedt het jou als leerkracht ook kansen om de kinderen in je klas nog beter te leren kennen, om zo te kunnen inspelen en verder bouwen op wat bij hen leeft.
In KleuterKracht vind je naast de agency-werkvormen ook een theoretische en didactische verantwoording die je in staat stelt om onderbouwde keuzes te maken in welke werkvormen je inzet en hoe je die aanpast naar je eigen context.
Elke werkvorm werd door peuter- en kleuteronderwijzers in de praktijk getest. Hun bevindingen en opmerkingen geven je een concreet en realistisch beeld van wat je mag verwachten wanneer je aan de slag gaat met dit boek.
KleuterKracht is het resultaat van onderzoek in het expertisecentrum Education & Development van UCLL Research & Expertise.
Anne Slaets is lector pedagogische wetenschappen, praktijkbegeleider en onderzoeker in de Hogeschool UCLL Bachelor Kleuteronderwijzer. Ze doet onderzoek naar specifieke thema’s rond het jonge kind zoals opvoedingsrelatie en agency.
Hilde Stroobants is onderzoeker, lector pedagogische wetenschappen, praktijkbegeleider en nascholingsdocent aan de Hogeschool UCLL. Haar focus in onderzoek ligt bij leer- en denkprocessen en bij het jonge kind. Ze geeft les in de Bachelor Kleuteronderwijzer.
Elke werkvorm is uitgeschreven als een stappenplan met een uitgesproken rol voor de kinderen om ideeën en inhoud aan te brengen, terwijl de structuur in de handen van de leerkracht ligt. Op die manier houd je als (aankomende) leerkracht het overzicht, terwijl er toch erg veel ruimte is voor de interesses en inbreng van de kinderen.
Inzetten op agency biedt heel wat ontwikkelingskansen bij jonge kinderen. Het heeft een positieve invloed op hun motivatie, zelfwaarde, probleemoplossende vaardigheden en nog veel meer. Het helpt hen op weg om op te komen voor wat ze belangrijk vinden, voor zichzelf, maar ook voor anderen, nu en ook later. Tegelijk biedt het jou als leerkracht ook kansen om de kinderen in je klas nog beter te leren kennen, om zo te kunnen inspelen en verder bouwen op wat bij hen leeft.
In KleuterKracht vind je naast de agency-werkvormen ook een theoretische en didactische verantwoording die je in staat stelt om onderbouwde keuzes te maken in welke werkvormen je inzet en hoe je die aanpast naar je eigen context.
Elke werkvorm werd door peuter- en kleuteronderwijzers in de praktijk getest. Hun bevindingen en opmerkingen geven je een concreet en realistisch beeld van wat je mag verwachten wanneer je aan de slag gaat met dit boek.
KleuterKracht is het resultaat van onderzoek in het expertisecentrum Education & Development van UCLL Research & Expertise.
Anne Slaets is lector pedagogische wetenschappen, praktijkbegeleider en onderzoeker in de Hogeschool UCLL Bachelor Kleuteronderwijzer. Ze doet onderzoek naar specifieke thema’s rond het jonge kind zoals opvoedingsrelatie en agency.
Hilde Stroobants is onderzoeker, lector pedagogische wetenschappen, praktijkbegeleider en nascholingsdocent aan de Hogeschool UCLL. Haar focus in onderzoek ligt bij leer- en denkprocessen en bij het jonge kind. Ze geeft les in de Bachelor Kleuteronderwijzer.
Daan. Een nieuw leven voor een sok met een gaatje
€ 22,00
Wil jij graag spannende of grappige avonturen beleven met je eigen sokpop?
Wil je graag een vriendje om geheimen mee te delen of… om samen boeken te lezen?
Wil jij zelf een sokpop knutselen?
Dan is dit boek voor jou!
Monique Marius heeft in haar lange loopbaan als onderwijzeres mogen ervaren hoe verzot kinderen zijn op hun zelfgemaakte sokpop. De sokpop is een veilige uitlaatklep voor hun emoties: de pop kan blij of verdrietig zijn. Kinderen die moeilijk of geen contact met je leggen, verwoorden zonder schroom hun gevoelens via de pop. De pop is ook hun partner om leerstof te verwerken: bij het lezen (bv. toneellezen) krijgt de pop meestal de moeilijkste of langste tekst. Kinderen oefenen dubbel, want ze lezen hun eigen deel en ook dat van de pop. En als ouders geen tijd hebben om thuis mee te oefenen, dan helpt de sokpop. En natuurlijk is de sokpop ook gewoon een leuk vriendje om alles mee te delen en om leuke avonturen mee te beleven!
Fantasie prikkelen, emoties verwerken, lezen stimuleren… de sokpop is MAGIE!
Als muzisch leerkracht beeld heeft Monique Marius een eenvoudige manier bedacht om samen met de kinderen een eigen sokpop te maken. Dit prentenboek bevat ook een duidelijk, geïllustreerd stappenplan om je eigen sokpop te maken.
Monique Marius was 42 jaar leerkracht (waarvan 11 jaar muzische vorming-beeld) in het buitengewoon lager onderwijs IVIO Salvator in Oostakker-Gent.
Wil je graag een vriendje om geheimen mee te delen of… om samen boeken te lezen?
Wil jij zelf een sokpop knutselen?
Dan is dit boek voor jou!
Monique Marius heeft in haar lange loopbaan als onderwijzeres mogen ervaren hoe verzot kinderen zijn op hun zelfgemaakte sokpop. De sokpop is een veilige uitlaatklep voor hun emoties: de pop kan blij of verdrietig zijn. Kinderen die moeilijk of geen contact met je leggen, verwoorden zonder schroom hun gevoelens via de pop. De pop is ook hun partner om leerstof te verwerken: bij het lezen (bv. toneellezen) krijgt de pop meestal de moeilijkste of langste tekst. Kinderen oefenen dubbel, want ze lezen hun eigen deel en ook dat van de pop. En als ouders geen tijd hebben om thuis mee te oefenen, dan helpt de sokpop. En natuurlijk is de sokpop ook gewoon een leuk vriendje om alles mee te delen en om leuke avonturen mee te beleven!
Fantasie prikkelen, emoties verwerken, lezen stimuleren… de sokpop is MAGIE!
Als muzisch leerkracht beeld heeft Monique Marius een eenvoudige manier bedacht om samen met de kinderen een eigen sokpop te maken. Dit prentenboek bevat ook een duidelijk, geïllustreerd stappenplan om je eigen sokpop te maken.
Monique Marius was 42 jaar leerkracht (waarvan 11 jaar muzische vorming-beeld) in het buitengewoon lager onderwijs IVIO Salvator in Oostakker-Gent.
Daan. Een nieuw leven voor een sok met een gaatje
€ 22,00
Wil jij graag spannende of grappige avonturen beleven met je eigen sokpop?
Wil je graag een vriendje om geheimen mee te delen of… om samen boeken te lezen?
Wil jij zelf een sokpop knutselen?
Dan is dit boek voor jou!
Monique Marius heeft in haar lange loopbaan als onderwijzeres mogen ervaren hoe verzot kinderen zijn op hun zelfgemaakte sokpop. De sokpop is een veilige uitlaatklep voor hun emoties: de pop kan blij of verdrietig zijn. Kinderen die moeilijk of geen contact met je leggen, verwoorden zonder schroom hun gevoelens via de pop. De pop is ook hun partner om leerstof te verwerken: bij het lezen (bv. toneellezen) krijgt de pop meestal de moeilijkste of langste tekst. Kinderen oefenen dubbel, want ze lezen hun eigen deel en ook dat van de pop. En als ouders geen tijd hebben om thuis mee te oefenen, dan helpt de sokpop. En natuurlijk is de sokpop ook gewoon een leuk vriendje om alles mee te delen en om leuke avonturen mee te beleven!
Fantasie prikkelen, emoties verwerken, lezen stimuleren… de sokpop is MAGIE!
Als muzisch leerkracht beeld heeft Monique Marius een eenvoudige manier bedacht om samen met de kinderen een eigen sokpop te maken. Dit prentenboek bevat ook een duidelijk, geïllustreerd stappenplan om je eigen sokpop te maken.
Monique Marius was 42 jaar leerkracht (waarvan 11 jaar muzische vorming-beeld) in het buitengewoon lager onderwijs IVIO Salvator in Oostakker-Gent.
Wil je graag een vriendje om geheimen mee te delen of… om samen boeken te lezen?
Wil jij zelf een sokpop knutselen?
Dan is dit boek voor jou!
Monique Marius heeft in haar lange loopbaan als onderwijzeres mogen ervaren hoe verzot kinderen zijn op hun zelfgemaakte sokpop. De sokpop is een veilige uitlaatklep voor hun emoties: de pop kan blij of verdrietig zijn. Kinderen die moeilijk of geen contact met je leggen, verwoorden zonder schroom hun gevoelens via de pop. De pop is ook hun partner om leerstof te verwerken: bij het lezen (bv. toneellezen) krijgt de pop meestal de moeilijkste of langste tekst. Kinderen oefenen dubbel, want ze lezen hun eigen deel en ook dat van de pop. En als ouders geen tijd hebben om thuis mee te oefenen, dan helpt de sokpop. En natuurlijk is de sokpop ook gewoon een leuk vriendje om alles mee te delen en om leuke avonturen mee te beleven!
Fantasie prikkelen, emoties verwerken, lezen stimuleren… de sokpop is MAGIE!
Als muzisch leerkracht beeld heeft Monique Marius een eenvoudige manier bedacht om samen met de kinderen een eigen sokpop te maken. Dit prentenboek bevat ook een duidelijk, geïllustreerd stappenplan om je eigen sokpop te maken.
Monique Marius was 42 jaar leerkracht (waarvan 11 jaar muzische vorming-beeld) in het buitengewoon lager onderwijs IVIO Salvator in Oostakker-Gent.
(Para)medische prestaties en (medische) laboratoria. Analyse inzake btw
€ 37,00
De medische en paramedische vrijstellingen zijn gekoppeld aan het therapeutisch doel van de prestatie. In dit boek wordt de reikwijdte hiervan geanalyseerd.
Bovendien komen ook de prestaties van laboratoria aan bod.
Wanneer moet er btw aangerekend worden en wanneer zijn de prestaties vrijgesteld? En welke zijn de btw-verplichtingen die hier desgevallend uit voortvloeien?
Het boek geeft de regelgeving en administratieve bronnen weer zoals die gelden vanaf 1 januari 2022.
Stefan Ruysschaert is werkzaam bij de FOD Financiën als Adviseur. Hij is docent btw en auteur van talrijke bijdragen op fiscaal vlak in toonaangevende tijdschriften en boeken. Hij is o.a. redactielid van TaxWin en het Tijdschrift Huur. Hij doceert het vak btw aan de faculteit Economische Wetenschappen van de UGent en is gastdocent aan de Hogeschool Gent en de Fiscale Hogeschool.
Bovendien komen ook de prestaties van laboratoria aan bod.
Wanneer moet er btw aangerekend worden en wanneer zijn de prestaties vrijgesteld? En welke zijn de btw-verplichtingen die hier desgevallend uit voortvloeien?
Het boek geeft de regelgeving en administratieve bronnen weer zoals die gelden vanaf 1 januari 2022.
Stefan Ruysschaert is werkzaam bij de FOD Financiën als Adviseur. Hij is docent btw en auteur van talrijke bijdragen op fiscaal vlak in toonaangevende tijdschriften en boeken. Hij is o.a. redactielid van TaxWin en het Tijdschrift Huur. Hij doceert het vak btw aan de faculteit Economische Wetenschappen van de UGent en is gastdocent aan de Hogeschool Gent en de Fiscale Hogeschool.
(Para)medische prestaties en (medische) laboratoria. Analyse inzake btw
€ 37,00
De medische en paramedische vrijstellingen zijn gekoppeld aan het therapeutisch doel van de prestatie. In dit boek wordt de reikwijdte hiervan geanalyseerd.
Bovendien komen ook de prestaties van laboratoria aan bod.
Wanneer moet er btw aangerekend worden en wanneer zijn de prestaties vrijgesteld? En welke zijn de btw-verplichtingen die hier desgevallend uit voortvloeien?
Het boek geeft de regelgeving en administratieve bronnen weer zoals die gelden vanaf 1 januari 2022.
Stefan Ruysschaert is werkzaam bij de FOD Financiën als Adviseur. Hij is docent btw en auteur van talrijke bijdragen op fiscaal vlak in toonaangevende tijdschriften en boeken. Hij is o.a. redactielid van TaxWin en het Tijdschrift Huur. Hij doceert het vak btw aan de faculteit Economische Wetenschappen van de UGent en is gastdocent aan de Hogeschool Gent en de Fiscale Hogeschool.
Bovendien komen ook de prestaties van laboratoria aan bod.
Wanneer moet er btw aangerekend worden en wanneer zijn de prestaties vrijgesteld? En welke zijn de btw-verplichtingen die hier desgevallend uit voortvloeien?
Het boek geeft de regelgeving en administratieve bronnen weer zoals die gelden vanaf 1 januari 2022.
Stefan Ruysschaert is werkzaam bij de FOD Financiën als Adviseur. Hij is docent btw en auteur van talrijke bijdragen op fiscaal vlak in toonaangevende tijdschriften en boeken. Hij is o.a. redactielid van TaxWin en het Tijdschrift Huur. Hij doceert het vak btw aan de faculteit Economische Wetenschappen van de UGent en is gastdocent aan de Hogeschool Gent en de Fiscale Hogeschool.
‘Voltooid leven’. Themanummer Filosofie & Praktijk – Jrg. 42 (2021) nr. 4.
€ 15,00
Inmiddels heeft de nieuwe regeringsploeg op het bordes gestaan. Een van de hete hangijzers die daarbij op de achtergrond aanwezig waren betreft het conceptwetsvoorstel 'voltooid leven', ingediend door Pia Dijkstra namens regeringspartij D66. In dit nummer van F&P is er aandacht voor dit thema, met als uitgangspunt de bijdrage “Een liberale, humanistische kritiek op een ‘voltooid leven’-wet” door Kevin Yuill. Op deze tekst van een lezing die Yuill eind vorig jaar hield, volgen korte commentaren van Maarten Verkerk, Ton Vink, Annemarieke van der Woude en Suzanne van den Eynden. Het geheel wordt kort ingeleid door Theo Boer. De teksten van de oorspronkelijk in het Engels gehouden voordrachten zijn naar het Nederlands vertaald, onder toevoeging van enkele voetnoten.
In zijn Minima Philosophica “De gevolgen van het escapisme voor het natuurbeleid” gaat Jozef Keulartz in op de zich steeds meer opdringende vraag naar de rechtvaardiging van de bijzondere positie die de mens zichzelf toekent ten opzicht van de wereld van dier én plant. Hoe groot mag dat verschil zijn? Hoe klein mag je het maken?
Een enigszins vergelijkbare thematiek wordt aangesneden in “Ik kan het niet alleen”, de bijdrage aan dit nummer van Jan Bransen. “Het hyper-individualistische mensbeeld dat we ons sinds de Verlichting hebben eigengemaakt staat op gespannen voet met het fundamentele besef dat ieder van ons een buitengewoon klein en kwetsbaar deel is van iets dat ontzaglijk veel groter is dan onszelf, zowel in materiële, sociale als existentiële zin.” En die positie heeft consequenties: “Onze vanzelfsprekende levenstaak– dat ieder van ons het eigen leven op eigen kracht tot een succes moet maken – lijkt niet te realiseren in een wereld die onder crises gebukt gaat: de vluchtelingencrisis, wooncrisis, energiecrisis, coronacrisis, schuldencrisis, volksvertegenwoordigingscrisis, ‘fake news’-crisis, klimaatcrisis.'' Ter geruststelling kan Bransen aan de titel van dit artikel: Ik kan het niet alleen toevoegen: ''Gelukkig hoef ik het ook niet alleen.''
Daarna blijft ook Michiel Korthals met zijn bijdrage “Het bijzondere van een deugdzaam mens” in dezelfde thematische omgeving. Korthals schreef zijn bijdrage in het kader van een essaywedstrijd die de Vereniging van Ethici in Nederland uitschreef bij gelegenheid van haar 50-jarig bestaan. De opdracht en uitdaging waarop Korthals met zijn prijswinnende essay reageerde, luidde: “schrijf een filosofische verhandeling voor of tegen de claim dat over deugdzame mensen niets boeiends te melden valt”. Zijn bijdrage bevat “een goed tegenvoorbeeld voor de luie uitspraak dat het leven van deugdzame mensen saai en langdradig is”. Immers: “Eén voorbeeld is voldoende om die nergens op gebaseerde universele uitspraak te falsifiëren.”
De rubriek Signalementen vormt zoals gebruikelijk de afsluiting van F&P.
Ton Vink
In zijn Minima Philosophica “De gevolgen van het escapisme voor het natuurbeleid” gaat Jozef Keulartz in op de zich steeds meer opdringende vraag naar de rechtvaardiging van de bijzondere positie die de mens zichzelf toekent ten opzicht van de wereld van dier én plant. Hoe groot mag dat verschil zijn? Hoe klein mag je het maken?
Een enigszins vergelijkbare thematiek wordt aangesneden in “Ik kan het niet alleen”, de bijdrage aan dit nummer van Jan Bransen. “Het hyper-individualistische mensbeeld dat we ons sinds de Verlichting hebben eigengemaakt staat op gespannen voet met het fundamentele besef dat ieder van ons een buitengewoon klein en kwetsbaar deel is van iets dat ontzaglijk veel groter is dan onszelf, zowel in materiële, sociale als existentiële zin.” En die positie heeft consequenties: “Onze vanzelfsprekende levenstaak– dat ieder van ons het eigen leven op eigen kracht tot een succes moet maken – lijkt niet te realiseren in een wereld die onder crises gebukt gaat: de vluchtelingencrisis, wooncrisis, energiecrisis, coronacrisis, schuldencrisis, volksvertegenwoordigingscrisis, ‘fake news’-crisis, klimaatcrisis.'' Ter geruststelling kan Bransen aan de titel van dit artikel: Ik kan het niet alleen toevoegen: ''Gelukkig hoef ik het ook niet alleen.''
Daarna blijft ook Michiel Korthals met zijn bijdrage “Het bijzondere van een deugdzaam mens” in dezelfde thematische omgeving. Korthals schreef zijn bijdrage in het kader van een essaywedstrijd die de Vereniging van Ethici in Nederland uitschreef bij gelegenheid van haar 50-jarig bestaan. De opdracht en uitdaging waarop Korthals met zijn prijswinnende essay reageerde, luidde: “schrijf een filosofische verhandeling voor of tegen de claim dat over deugdzame mensen niets boeiends te melden valt”. Zijn bijdrage bevat “een goed tegenvoorbeeld voor de luie uitspraak dat het leven van deugdzame mensen saai en langdradig is”. Immers: “Eén voorbeeld is voldoende om die nergens op gebaseerde universele uitspraak te falsifiëren.”
De rubriek Signalementen vormt zoals gebruikelijk de afsluiting van F&P.
Ton Vink
‘Voltooid leven’. Themanummer Filosofie & Praktijk – Jrg. 42 (2021) nr. 4.
€ 15,00
Inmiddels heeft de nieuwe regeringsploeg op het bordes gestaan. Een van de hete hangijzers die daarbij op de achtergrond aanwezig waren betreft het conceptwetsvoorstel 'voltooid leven', ingediend door Pia Dijkstra namens regeringspartij D66. In dit nummer van F&P is er aandacht voor dit thema, met als uitgangspunt de bijdrage “Een liberale, humanistische kritiek op een ‘voltooid leven’-wet” door Kevin Yuill. Op deze tekst van een lezing die Yuill eind vorig jaar hield, volgen korte commentaren van Maarten Verkerk, Ton Vink, Annemarieke van der Woude en Suzanne van den Eynden. Het geheel wordt kort ingeleid door Theo Boer. De teksten van de oorspronkelijk in het Engels gehouden voordrachten zijn naar het Nederlands vertaald, onder toevoeging van enkele voetnoten.
In zijn Minima Philosophica “De gevolgen van het escapisme voor het natuurbeleid” gaat Jozef Keulartz in op de zich steeds meer opdringende vraag naar de rechtvaardiging van de bijzondere positie die de mens zichzelf toekent ten opzicht van de wereld van dier én plant. Hoe groot mag dat verschil zijn? Hoe klein mag je het maken?
Een enigszins vergelijkbare thematiek wordt aangesneden in “Ik kan het niet alleen”, de bijdrage aan dit nummer van Jan Bransen. “Het hyper-individualistische mensbeeld dat we ons sinds de Verlichting hebben eigengemaakt staat op gespannen voet met het fundamentele besef dat ieder van ons een buitengewoon klein en kwetsbaar deel is van iets dat ontzaglijk veel groter is dan onszelf, zowel in materiële, sociale als existentiële zin.” En die positie heeft consequenties: “Onze vanzelfsprekende levenstaak– dat ieder van ons het eigen leven op eigen kracht tot een succes moet maken – lijkt niet te realiseren in een wereld die onder crises gebukt gaat: de vluchtelingencrisis, wooncrisis, energiecrisis, coronacrisis, schuldencrisis, volksvertegenwoordigingscrisis, ‘fake news’-crisis, klimaatcrisis.'' Ter geruststelling kan Bransen aan de titel van dit artikel: Ik kan het niet alleen toevoegen: ''Gelukkig hoef ik het ook niet alleen.''
Daarna blijft ook Michiel Korthals met zijn bijdrage “Het bijzondere van een deugdzaam mens” in dezelfde thematische omgeving. Korthals schreef zijn bijdrage in het kader van een essaywedstrijd die de Vereniging van Ethici in Nederland uitschreef bij gelegenheid van haar 50-jarig bestaan. De opdracht en uitdaging waarop Korthals met zijn prijswinnende essay reageerde, luidde: “schrijf een filosofische verhandeling voor of tegen de claim dat over deugdzame mensen niets boeiends te melden valt”. Zijn bijdrage bevat “een goed tegenvoorbeeld voor de luie uitspraak dat het leven van deugdzame mensen saai en langdradig is”. Immers: “Eén voorbeeld is voldoende om die nergens op gebaseerde universele uitspraak te falsifiëren.”
De rubriek Signalementen vormt zoals gebruikelijk de afsluiting van F&P.
Ton Vink
In zijn Minima Philosophica “De gevolgen van het escapisme voor het natuurbeleid” gaat Jozef Keulartz in op de zich steeds meer opdringende vraag naar de rechtvaardiging van de bijzondere positie die de mens zichzelf toekent ten opzicht van de wereld van dier én plant. Hoe groot mag dat verschil zijn? Hoe klein mag je het maken?
Een enigszins vergelijkbare thematiek wordt aangesneden in “Ik kan het niet alleen”, de bijdrage aan dit nummer van Jan Bransen. “Het hyper-individualistische mensbeeld dat we ons sinds de Verlichting hebben eigengemaakt staat op gespannen voet met het fundamentele besef dat ieder van ons een buitengewoon klein en kwetsbaar deel is van iets dat ontzaglijk veel groter is dan onszelf, zowel in materiële, sociale als existentiële zin.” En die positie heeft consequenties: “Onze vanzelfsprekende levenstaak– dat ieder van ons het eigen leven op eigen kracht tot een succes moet maken – lijkt niet te realiseren in een wereld die onder crises gebukt gaat: de vluchtelingencrisis, wooncrisis, energiecrisis, coronacrisis, schuldencrisis, volksvertegenwoordigingscrisis, ‘fake news’-crisis, klimaatcrisis.'' Ter geruststelling kan Bransen aan de titel van dit artikel: Ik kan het niet alleen toevoegen: ''Gelukkig hoef ik het ook niet alleen.''
Daarna blijft ook Michiel Korthals met zijn bijdrage “Het bijzondere van een deugdzaam mens” in dezelfde thematische omgeving. Korthals schreef zijn bijdrage in het kader van een essaywedstrijd die de Vereniging van Ethici in Nederland uitschreef bij gelegenheid van haar 50-jarig bestaan. De opdracht en uitdaging waarop Korthals met zijn prijswinnende essay reageerde, luidde: “schrijf een filosofische verhandeling voor of tegen de claim dat over deugdzame mensen niets boeiends te melden valt”. Zijn bijdrage bevat “een goed tegenvoorbeeld voor de luie uitspraak dat het leven van deugdzame mensen saai en langdradig is”. Immers: “Eén voorbeeld is voldoende om die nergens op gebaseerde universele uitspraak te falsifiëren.”
De rubriek Signalementen vormt zoals gebruikelijk de afsluiting van F&P.
Ton Vink
Douane – Bronnenboek – bijgewerkt tot 3 januari 2022
€ 55,00
Dit Bronnenboek bevat de gecoördineerde versie van de Algemene wet inzake douane en accijnzen, het Europees Douanewetboek, de uitvoeringsbesluiten en -verordeningen, en de wetgeving inzake douanevertegenwoordiging, bijgewerkt tot 3 januari 2022.
In dit boek vindt u, naast de fiscale bepalingen en de praktische uitvoering ervan, ook alle informatie over de procedure bij inbreuken en het betwisten van boetes (bezwaar, fiscale bemiddeling, correctionele rechtbank, ...).
Ondernemers en handelaars, douaneambtenaren, overheden, bedrijfsjuristen, rechtspractici, studenten en economische beroepen beschikken met dit zakwetboekje over een accurate, zeer recente en voordelige tekstuitgave.
In dit boek vindt u, naast de fiscale bepalingen en de praktische uitvoering ervan, ook alle informatie over de procedure bij inbreuken en het betwisten van boetes (bezwaar, fiscale bemiddeling, correctionele rechtbank, ...).
Ondernemers en handelaars, douaneambtenaren, overheden, bedrijfsjuristen, rechtspractici, studenten en economische beroepen beschikken met dit zakwetboekje over een accurate, zeer recente en voordelige tekstuitgave.
Douane – Bronnenboek – bijgewerkt tot 3 januari 2022
€ 55,00
Dit Bronnenboek bevat de gecoördineerde versie van de Algemene wet inzake douane en accijnzen, het Europees Douanewetboek, de uitvoeringsbesluiten en -verordeningen, en de wetgeving inzake douanevertegenwoordiging, bijgewerkt tot 3 januari 2022.
In dit boek vindt u, naast de fiscale bepalingen en de praktische uitvoering ervan, ook alle informatie over de procedure bij inbreuken en het betwisten van boetes (bezwaar, fiscale bemiddeling, correctionele rechtbank, ...).
Ondernemers en handelaars, douaneambtenaren, overheden, bedrijfsjuristen, rechtspractici, studenten en economische beroepen beschikken met dit zakwetboekje over een accurate, zeer recente en voordelige tekstuitgave.
In dit boek vindt u, naast de fiscale bepalingen en de praktische uitvoering ervan, ook alle informatie over de procedure bij inbreuken en het betwisten van boetes (bezwaar, fiscale bemiddeling, correctionele rechtbank, ...).
Ondernemers en handelaars, douaneambtenaren, overheden, bedrijfsjuristen, rechtspractici, studenten en economische beroepen beschikken met dit zakwetboekje over een accurate, zeer recente en voordelige tekstuitgave.
Bedrijfskunde – de essentie (4e gewijzigde ed.)
€ 70,00
Wie de ambitie heeft om te gaan ondernemen of dat al doet, moet van vele markten op zijn minst een behoorlijke basiskennis hebben. Deze uitgave brengt die kennis bij elkaar. Na een inleidend hoofdstuk over wat ondernemen wil zeggen, overloopt ze één na één alle essentiële elementen, zoals belangrijke economische begrippen,
vennootschapsvormen met speciale aandacht voor de ‘handelszaak’, boekhouding, jaarrekening, kostprijscalculatie, investering, budgettering, financiële analyse,… Een apart hoofdstuk is besteed aan het opstarten van een eigen onderneming.
De auteur voegt vele voorbeelden en cases toe. Zo wordt de jaarrekening besproken aan de hand van reële gegevens van een bestaand bedrijf.
“Dit boek lijkt dik, maar leest als een trein...”
Robin Demeeter, ondernemer pur sang
“Als je het reilen en zeilen van een onderneming wil kennen, is dit boek echt de moeite”
Prof. dr. Ronald Buyl
“Poelaert verstaat de kunst om concrete zaken in verband met de onderneming aan te brengen. Geen overbodige ballast ... alleen de kern van bedrijfseconomie wordt toegelicht. Het hoofdstuk over boekhouden en kostprijscalculatie is een juweeltje van pedagogische aanpak. Eerst kort de theorie en dan onmiddellijk toegepast in realistische cases.”
Francis Cornelis, boekhouder
“Dit boek puilt uit van concrete en toepasbare bedrijfskundige concepten. De opbouw van het boek is zodanig dat de lezer stap voor stap inzicht krijgt in de operationele en fnanciële werking van de onderneming. Kostprijscalculatie wordt vaak gezien als een moeilijke opdracht. Met dit boek krijgt de lezer tools in handen die het berekenen van kostprijzen van producten plots eenvoudig maken...”
Karel van den Berghe, bedrijfsleider Globis
“Een must voor elke verantwoordelijke manager...”
Lode Degeyter, algemeen directeur van de Hogeschool West-Vlaanderen
“Dit schitterende boek kan ik elke beginnende ondernemer aanraden.”
Steve Stevens, ondernemer en manager Durf Ondernemen UGent
“Beschouw dit werk maar als een referentie in de beginselen van bedrijfseconomie. De verdienste is vooral dat het boek elke ondernemer en manager zal weten te prikkelen: van economische concepten tot vennootschapsvormen over kostprijscalculatie en fnanciële analyse van de onderneming. Alles wordt in een bevattelijke taal concreet en helder gebracht. Een aanrader...”
Kurt Cofyn, Chief Operating Ofcer Cargill
“Ondernemen is risico durven nemen. Ondernemen is durven buiten de lijntjes kleuren. Ondernemen vereist daarnaast ook grondige kennis van de economische context waarbinnen men opereert. Verder is men het aan zichzelf verplicht om een minimum aan fnanciële bagage te hebben. Dit vlot geschreven boek helpt je moeiteloos op weg...”
Pol Descamps, oud-directeur-beheerder eigenaar Barco Industries
“Bedrijfskunde is een breed studiegebied. Poelaert is erin geslaagd om de 5 kernaspecten ervan duidelijk en helder te belichten. De cases geven duidelijk inzicht in soms complexe vraagstukken...”
Dirk Laverge, docent economie aan de Hogeschool West-Vlaanderen
-- Heb jij de nodige ondernemersvaardigheden? Test het in dit boek.
Moet ik echt een bvba’tje opzetten of doe ik gewoon een eenmanszaak? Is een eenmanszaak belast via de personenbelasting of via de vennootschapsbelasting?
Hoe lees ik een balans? En een resultatenrekening?
Hoe wordt de winst in de onderneming uiteindelijk “bestemd”?
Afschrijven? Waarom doet men dat? Wat is het nut voor de vennootschap ervan? Waarom zijn afschrijvingskosten geen kaskosten en zijn kosten van huur dat wel?
Als ik als ondernemer iemand aanneem als bediende, wat is dan grosso modo de kost van die persoon voor de onderneming?
Ik maak in mijn onderneming winst kwartaal na kwartaal. Toch staat er op de bankrekening van de onderneming onvoldoende geld. Hoe komt dat toch?
Ik wil een onderneming starten en heb schrik van alle administratieve rompslomp. Waar kan ik terecht?
Hoe kan ik als ondernemer beter mijn boekhouder begrijpen, opvolgen en zelfs kritisch “teasen”?
Moet ik echt een boekhouding kunnen voeren om te ondernemen?
Ik wil investeren in een machine. Hoe bereken ik het rendement van mijn investering?
Hoe kan ik als ondernemer de kost van mijn producten/diensten/departementen berekenen?
Het zijn allemaal praktische vragen waarop je in dit boek een helder antwoord krijgt.
.Ludo Poelaert</b is professor bedrijfseconomie, bedrijfsmanagement en ondernemerschap aan de UGent, faculteit Toegepaste Wetenschappen.
Tevens staat hij met beide voeten in het bedrijfsleven en leidt hij een onderneming die zich toespitst op het coachen van managers en zelfstandigen. De ervaring hiervoor haalde hij uit zijn verleden als manager in diverse topondernemingen, zoals Apple Computer, Air Belgium, Adecco en Barry Callebaut.
Ludo deed ervaring op als verkoper, business unit manager, algemeen directeur, vicepresident en afgevaardigd bestuurder. Zo leerde hij het “management metier” door en door kennen.
In navolging van zijn eerste boek “Financieel beheer voor managers”, eveneens uitgegeven door Garant, schreef hij dit basiswerk Bedrijfskunde | De essentie.
De auteur voegt vele voorbeelden en cases toe. Zo wordt de jaarrekening besproken aan de hand van reële gegevens van een bestaand bedrijf.
“Dit boek lijkt dik, maar leest als een trein...”
Robin Demeeter, ondernemer pur sang
“Als je het reilen en zeilen van een onderneming wil kennen, is dit boek echt de moeite”
Prof. dr. Ronald Buyl
“Poelaert verstaat de kunst om concrete zaken in verband met de onderneming aan te brengen. Geen overbodige ballast ... alleen de kern van bedrijfseconomie wordt toegelicht. Het hoofdstuk over boekhouden en kostprijscalculatie is een juweeltje van pedagogische aanpak. Eerst kort de theorie en dan onmiddellijk toegepast in realistische cases.”
Francis Cornelis, boekhouder
“Dit boek puilt uit van concrete en toepasbare bedrijfskundige concepten. De opbouw van het boek is zodanig dat de lezer stap voor stap inzicht krijgt in de operationele en fnanciële werking van de onderneming. Kostprijscalculatie wordt vaak gezien als een moeilijke opdracht. Met dit boek krijgt de lezer tools in handen die het berekenen van kostprijzen van producten plots eenvoudig maken...”
Karel van den Berghe, bedrijfsleider Globis
“Een must voor elke verantwoordelijke manager...”
Lode Degeyter, algemeen directeur van de Hogeschool West-Vlaanderen
“Dit schitterende boek kan ik elke beginnende ondernemer aanraden.”
Steve Stevens, ondernemer en manager Durf Ondernemen UGent
“Beschouw dit werk maar als een referentie in de beginselen van bedrijfseconomie. De verdienste is vooral dat het boek elke ondernemer en manager zal weten te prikkelen: van economische concepten tot vennootschapsvormen over kostprijscalculatie en fnanciële analyse van de onderneming. Alles wordt in een bevattelijke taal concreet en helder gebracht. Een aanrader...”
Kurt Cofyn, Chief Operating Ofcer Cargill
“Ondernemen is risico durven nemen. Ondernemen is durven buiten de lijntjes kleuren. Ondernemen vereist daarnaast ook grondige kennis van de economische context waarbinnen men opereert. Verder is men het aan zichzelf verplicht om een minimum aan fnanciële bagage te hebben. Dit vlot geschreven boek helpt je moeiteloos op weg...”
Pol Descamps, oud-directeur-beheerder eigenaar Barco Industries
“Bedrijfskunde is een breed studiegebied. Poelaert is erin geslaagd om de 5 kernaspecten ervan duidelijk en helder te belichten. De cases geven duidelijk inzicht in soms complexe vraagstukken...”
Dirk Laverge, docent economie aan de Hogeschool West-Vlaanderen
-- Heb jij de nodige ondernemersvaardigheden? Test het in dit boek.
Moet ik echt een bvba’tje opzetten of doe ik gewoon een eenmanszaak? Is een eenmanszaak belast via de personenbelasting of via de vennootschapsbelasting?
Hoe lees ik een balans? En een resultatenrekening?
Hoe wordt de winst in de onderneming uiteindelijk “bestemd”?
Afschrijven? Waarom doet men dat? Wat is het nut voor de vennootschap ervan? Waarom zijn afschrijvingskosten geen kaskosten en zijn kosten van huur dat wel?
Als ik als ondernemer iemand aanneem als bediende, wat is dan grosso modo de kost van die persoon voor de onderneming?
Ik maak in mijn onderneming winst kwartaal na kwartaal. Toch staat er op de bankrekening van de onderneming onvoldoende geld. Hoe komt dat toch?
Ik wil een onderneming starten en heb schrik van alle administratieve rompslomp. Waar kan ik terecht?
Hoe kan ik als ondernemer beter mijn boekhouder begrijpen, opvolgen en zelfs kritisch “teasen”?
Moet ik echt een boekhouding kunnen voeren om te ondernemen?
Ik wil investeren in een machine. Hoe bereken ik het rendement van mijn investering?
Hoe kan ik als ondernemer de kost van mijn producten/diensten/departementen berekenen?
Het zijn allemaal praktische vragen waarop je in dit boek een helder antwoord krijgt.
.Ludo Poelaert</b is professor bedrijfseconomie, bedrijfsmanagement en ondernemerschap aan de UGent, faculteit Toegepaste Wetenschappen.
Tevens staat hij met beide voeten in het bedrijfsleven en leidt hij een onderneming die zich toespitst op het coachen van managers en zelfstandigen. De ervaring hiervoor haalde hij uit zijn verleden als manager in diverse topondernemingen, zoals Apple Computer, Air Belgium, Adecco en Barry Callebaut.
Ludo deed ervaring op als verkoper, business unit manager, algemeen directeur, vicepresident en afgevaardigd bestuurder. Zo leerde hij het “management metier” door en door kennen.
In navolging van zijn eerste boek “Financieel beheer voor managers”, eveneens uitgegeven door Garant, schreef hij dit basiswerk Bedrijfskunde | De essentie.
Bedrijfskunde – de essentie (4e gewijzigde ed.)
€ 70,00
Wie de ambitie heeft om te gaan ondernemen of dat al doet, moet van vele markten op zijn minst een behoorlijke basiskennis hebben. Deze uitgave brengt die kennis bij elkaar. Na een inleidend hoofdstuk over wat ondernemen wil zeggen, overloopt ze één na één alle essentiële elementen, zoals belangrijke economische begrippen,
vennootschapsvormen met speciale aandacht voor de ‘handelszaak’, boekhouding, jaarrekening, kostprijscalculatie, investering, budgettering, financiële analyse,… Een apart hoofdstuk is besteed aan het opstarten van een eigen onderneming.
De auteur voegt vele voorbeelden en cases toe. Zo wordt de jaarrekening besproken aan de hand van reële gegevens van een bestaand bedrijf.
“Dit boek lijkt dik, maar leest als een trein...”
Robin Demeeter, ondernemer pur sang
“Als je het reilen en zeilen van een onderneming wil kennen, is dit boek echt de moeite”
Prof. dr. Ronald Buyl
“Poelaert verstaat de kunst om concrete zaken in verband met de onderneming aan te brengen. Geen overbodige ballast ... alleen de kern van bedrijfseconomie wordt toegelicht. Het hoofdstuk over boekhouden en kostprijscalculatie is een juweeltje van pedagogische aanpak. Eerst kort de theorie en dan onmiddellijk toegepast in realistische cases.”
Francis Cornelis, boekhouder
“Dit boek puilt uit van concrete en toepasbare bedrijfskundige concepten. De opbouw van het boek is zodanig dat de lezer stap voor stap inzicht krijgt in de operationele en fnanciële werking van de onderneming. Kostprijscalculatie wordt vaak gezien als een moeilijke opdracht. Met dit boek krijgt de lezer tools in handen die het berekenen van kostprijzen van producten plots eenvoudig maken...”
Karel van den Berghe, bedrijfsleider Globis
“Een must voor elke verantwoordelijke manager...”
Lode Degeyter, algemeen directeur van de Hogeschool West-Vlaanderen
“Dit schitterende boek kan ik elke beginnende ondernemer aanraden.”
Steve Stevens, ondernemer en manager Durf Ondernemen UGent
“Beschouw dit werk maar als een referentie in de beginselen van bedrijfseconomie. De verdienste is vooral dat het boek elke ondernemer en manager zal weten te prikkelen: van economische concepten tot vennootschapsvormen over kostprijscalculatie en fnanciële analyse van de onderneming. Alles wordt in een bevattelijke taal concreet en helder gebracht. Een aanrader...”
Kurt Cofyn, Chief Operating Ofcer Cargill
“Ondernemen is risico durven nemen. Ondernemen is durven buiten de lijntjes kleuren. Ondernemen vereist daarnaast ook grondige kennis van de economische context waarbinnen men opereert. Verder is men het aan zichzelf verplicht om een minimum aan fnanciële bagage te hebben. Dit vlot geschreven boek helpt je moeiteloos op weg...”
Pol Descamps, oud-directeur-beheerder eigenaar Barco Industries
“Bedrijfskunde is een breed studiegebied. Poelaert is erin geslaagd om de 5 kernaspecten ervan duidelijk en helder te belichten. De cases geven duidelijk inzicht in soms complexe vraagstukken...”
Dirk Laverge, docent economie aan de Hogeschool West-Vlaanderen
-- Heb jij de nodige ondernemersvaardigheden? Test het in dit boek.
Moet ik echt een bvba’tje opzetten of doe ik gewoon een eenmanszaak? Is een eenmanszaak belast via de personenbelasting of via de vennootschapsbelasting?
Hoe lees ik een balans? En een resultatenrekening?
Hoe wordt de winst in de onderneming uiteindelijk “bestemd”?
Afschrijven? Waarom doet men dat? Wat is het nut voor de vennootschap ervan? Waarom zijn afschrijvingskosten geen kaskosten en zijn kosten van huur dat wel?
Als ik als ondernemer iemand aanneem als bediende, wat is dan grosso modo de kost van die persoon voor de onderneming?
Ik maak in mijn onderneming winst kwartaal na kwartaal. Toch staat er op de bankrekening van de onderneming onvoldoende geld. Hoe komt dat toch?
Ik wil een onderneming starten en heb schrik van alle administratieve rompslomp. Waar kan ik terecht?
Hoe kan ik als ondernemer beter mijn boekhouder begrijpen, opvolgen en zelfs kritisch “teasen”?
Moet ik echt een boekhouding kunnen voeren om te ondernemen?
Ik wil investeren in een machine. Hoe bereken ik het rendement van mijn investering?
Hoe kan ik als ondernemer de kost van mijn producten/diensten/departementen berekenen?
Het zijn allemaal praktische vragen waarop je in dit boek een helder antwoord krijgt.
.Ludo Poelaert</b is professor bedrijfseconomie, bedrijfsmanagement en ondernemerschap aan de UGent, faculteit Toegepaste Wetenschappen.
Tevens staat hij met beide voeten in het bedrijfsleven en leidt hij een onderneming die zich toespitst op het coachen van managers en zelfstandigen. De ervaring hiervoor haalde hij uit zijn verleden als manager in diverse topondernemingen, zoals Apple Computer, Air Belgium, Adecco en Barry Callebaut.
Ludo deed ervaring op als verkoper, business unit manager, algemeen directeur, vicepresident en afgevaardigd bestuurder. Zo leerde hij het “management metier” door en door kennen.
In navolging van zijn eerste boek “Financieel beheer voor managers”, eveneens uitgegeven door Garant, schreef hij dit basiswerk Bedrijfskunde | De essentie.
De auteur voegt vele voorbeelden en cases toe. Zo wordt de jaarrekening besproken aan de hand van reële gegevens van een bestaand bedrijf.
“Dit boek lijkt dik, maar leest als een trein...”
Robin Demeeter, ondernemer pur sang
“Als je het reilen en zeilen van een onderneming wil kennen, is dit boek echt de moeite”
Prof. dr. Ronald Buyl
“Poelaert verstaat de kunst om concrete zaken in verband met de onderneming aan te brengen. Geen overbodige ballast ... alleen de kern van bedrijfseconomie wordt toegelicht. Het hoofdstuk over boekhouden en kostprijscalculatie is een juweeltje van pedagogische aanpak. Eerst kort de theorie en dan onmiddellijk toegepast in realistische cases.”
Francis Cornelis, boekhouder
“Dit boek puilt uit van concrete en toepasbare bedrijfskundige concepten. De opbouw van het boek is zodanig dat de lezer stap voor stap inzicht krijgt in de operationele en fnanciële werking van de onderneming. Kostprijscalculatie wordt vaak gezien als een moeilijke opdracht. Met dit boek krijgt de lezer tools in handen die het berekenen van kostprijzen van producten plots eenvoudig maken...”
Karel van den Berghe, bedrijfsleider Globis
“Een must voor elke verantwoordelijke manager...”
Lode Degeyter, algemeen directeur van de Hogeschool West-Vlaanderen
“Dit schitterende boek kan ik elke beginnende ondernemer aanraden.”
Steve Stevens, ondernemer en manager Durf Ondernemen UGent
“Beschouw dit werk maar als een referentie in de beginselen van bedrijfseconomie. De verdienste is vooral dat het boek elke ondernemer en manager zal weten te prikkelen: van economische concepten tot vennootschapsvormen over kostprijscalculatie en fnanciële analyse van de onderneming. Alles wordt in een bevattelijke taal concreet en helder gebracht. Een aanrader...”
Kurt Cofyn, Chief Operating Ofcer Cargill
“Ondernemen is risico durven nemen. Ondernemen is durven buiten de lijntjes kleuren. Ondernemen vereist daarnaast ook grondige kennis van de economische context waarbinnen men opereert. Verder is men het aan zichzelf verplicht om een minimum aan fnanciële bagage te hebben. Dit vlot geschreven boek helpt je moeiteloos op weg...”
Pol Descamps, oud-directeur-beheerder eigenaar Barco Industries
“Bedrijfskunde is een breed studiegebied. Poelaert is erin geslaagd om de 5 kernaspecten ervan duidelijk en helder te belichten. De cases geven duidelijk inzicht in soms complexe vraagstukken...”
Dirk Laverge, docent economie aan de Hogeschool West-Vlaanderen
-- Heb jij de nodige ondernemersvaardigheden? Test het in dit boek.
Moet ik echt een bvba’tje opzetten of doe ik gewoon een eenmanszaak? Is een eenmanszaak belast via de personenbelasting of via de vennootschapsbelasting?
Hoe lees ik een balans? En een resultatenrekening?
Hoe wordt de winst in de onderneming uiteindelijk “bestemd”?
Afschrijven? Waarom doet men dat? Wat is het nut voor de vennootschap ervan? Waarom zijn afschrijvingskosten geen kaskosten en zijn kosten van huur dat wel?
Als ik als ondernemer iemand aanneem als bediende, wat is dan grosso modo de kost van die persoon voor de onderneming?
Ik maak in mijn onderneming winst kwartaal na kwartaal. Toch staat er op de bankrekening van de onderneming onvoldoende geld. Hoe komt dat toch?
Ik wil een onderneming starten en heb schrik van alle administratieve rompslomp. Waar kan ik terecht?
Hoe kan ik als ondernemer beter mijn boekhouder begrijpen, opvolgen en zelfs kritisch “teasen”?
Moet ik echt een boekhouding kunnen voeren om te ondernemen?
Ik wil investeren in een machine. Hoe bereken ik het rendement van mijn investering?
Hoe kan ik als ondernemer de kost van mijn producten/diensten/departementen berekenen?
Het zijn allemaal praktische vragen waarop je in dit boek een helder antwoord krijgt.
.Ludo Poelaert</b is professor bedrijfseconomie, bedrijfsmanagement en ondernemerschap aan de UGent, faculteit Toegepaste Wetenschappen.
Tevens staat hij met beide voeten in het bedrijfsleven en leidt hij een onderneming die zich toespitst op het coachen van managers en zelfstandigen. De ervaring hiervoor haalde hij uit zijn verleden als manager in diverse topondernemingen, zoals Apple Computer, Air Belgium, Adecco en Barry Callebaut.
Ludo deed ervaring op als verkoper, business unit manager, algemeen directeur, vicepresident en afgevaardigd bestuurder. Zo leerde hij het “management metier” door en door kennen.
In navolging van zijn eerste boek “Financieel beheer voor managers”, eveneens uitgegeven door Garant, schreef hij dit basiswerk Bedrijfskunde | De essentie.
Themanr Kleio jrg. 51 nr. 1/2. (jan.-apr.2022). Feestnummer bis. Vijftig jaar Kleio!
€ 10,00
Feestnummer bis
Kleio's gouden jubileum resulteerde vorige jaargang in een themanummer, dat hier een vervolg krijgt.
Met de rubriek 'In de spits' bieden we ook in dit nummer zicht op belangrijke recente tendensen in het brede domein van de klassieke studies: mentaliteitsgeschiedenis in een wereld van 'woke', huidige trends in de studie van de retoriek van de Romeinse late republiek, aandacht voor valentiegrammatica, typologie en computationele benaderingen in de Griekse taalkunde, hoe de papyroloog op de digitale trein is gestapt, evoluties in het onderzoek naar de interpretatiegeschiedenis van het Romeins recht aan middeleeuwse en vroegmoderne universiteiten, hoe geografische computertechnieken onze kennis over Romeinse wegenbouw verrijken, hoe de Neolatijnse studies ons o.a. verrassen met literaire creaties in genres als het epos en de science fiction, hoe receptiegeschiedenis vandaag de vinger legt op eeuwenlang gebruik van de klassieken ter promotie van een eurocentrisch wereldbeeld en tegelijk een nieuw, ruimer perspectief biedt.
De rubriek 'Onbekend, onbemind' promoot teksten die niet tot de typische schoolcanon behoren. Ook het artikel van Tom Ingelbrecht over de Narcissus van John Clapham sluit daarbij aan. In het luik 'Publieke stemmen' geven prominente deelnemers aan het cultureel-maatschappelijk debat mee hoe ze vandaag tegen de klassieken als discipline en als schoolvak aankijken. De klassieke talen en antieke culturen blijven duidelijk inspireren.
Koen Vandendriessche
Kleio's gouden jubileum resulteerde vorige jaargang in een themanummer, dat hier een vervolg krijgt.
Met de rubriek 'In de spits' bieden we ook in dit nummer zicht op belangrijke recente tendensen in het brede domein van de klassieke studies: mentaliteitsgeschiedenis in een wereld van 'woke', huidige trends in de studie van de retoriek van de Romeinse late republiek, aandacht voor valentiegrammatica, typologie en computationele benaderingen in de Griekse taalkunde, hoe de papyroloog op de digitale trein is gestapt, evoluties in het onderzoek naar de interpretatiegeschiedenis van het Romeins recht aan middeleeuwse en vroegmoderne universiteiten, hoe geografische computertechnieken onze kennis over Romeinse wegenbouw verrijken, hoe de Neolatijnse studies ons o.a. verrassen met literaire creaties in genres als het epos en de science fiction, hoe receptiegeschiedenis vandaag de vinger legt op eeuwenlang gebruik van de klassieken ter promotie van een eurocentrisch wereldbeeld en tegelijk een nieuw, ruimer perspectief biedt.
De rubriek 'Onbekend, onbemind' promoot teksten die niet tot de typische schoolcanon behoren. Ook het artikel van Tom Ingelbrecht over de Narcissus van John Clapham sluit daarbij aan. In het luik 'Publieke stemmen' geven prominente deelnemers aan het cultureel-maatschappelijk debat mee hoe ze vandaag tegen de klassieken als discipline en als schoolvak aankijken. De klassieke talen en antieke culturen blijven duidelijk inspireren.
Koen Vandendriessche
Themanr Kleio jrg. 51 nr. 1/2. (jan.-apr.2022). Feestnummer bis. Vijftig jaar Kleio!
€ 10,00
Feestnummer bis
Kleio's gouden jubileum resulteerde vorige jaargang in een themanummer, dat hier een vervolg krijgt.
Met de rubriek 'In de spits' bieden we ook in dit nummer zicht op belangrijke recente tendensen in het brede domein van de klassieke studies: mentaliteitsgeschiedenis in een wereld van 'woke', huidige trends in de studie van de retoriek van de Romeinse late republiek, aandacht voor valentiegrammatica, typologie en computationele benaderingen in de Griekse taalkunde, hoe de papyroloog op de digitale trein is gestapt, evoluties in het onderzoek naar de interpretatiegeschiedenis van het Romeins recht aan middeleeuwse en vroegmoderne universiteiten, hoe geografische computertechnieken onze kennis over Romeinse wegenbouw verrijken, hoe de Neolatijnse studies ons o.a. verrassen met literaire creaties in genres als het epos en de science fiction, hoe receptiegeschiedenis vandaag de vinger legt op eeuwenlang gebruik van de klassieken ter promotie van een eurocentrisch wereldbeeld en tegelijk een nieuw, ruimer perspectief biedt.
De rubriek 'Onbekend, onbemind' promoot teksten die niet tot de typische schoolcanon behoren. Ook het artikel van Tom Ingelbrecht over de Narcissus van John Clapham sluit daarbij aan. In het luik 'Publieke stemmen' geven prominente deelnemers aan het cultureel-maatschappelijk debat mee hoe ze vandaag tegen de klassieken als discipline en als schoolvak aankijken. De klassieke talen en antieke culturen blijven duidelijk inspireren.
Koen Vandendriessche
Kleio's gouden jubileum resulteerde vorige jaargang in een themanummer, dat hier een vervolg krijgt.
Met de rubriek 'In de spits' bieden we ook in dit nummer zicht op belangrijke recente tendensen in het brede domein van de klassieke studies: mentaliteitsgeschiedenis in een wereld van 'woke', huidige trends in de studie van de retoriek van de Romeinse late republiek, aandacht voor valentiegrammatica, typologie en computationele benaderingen in de Griekse taalkunde, hoe de papyroloog op de digitale trein is gestapt, evoluties in het onderzoek naar de interpretatiegeschiedenis van het Romeins recht aan middeleeuwse en vroegmoderne universiteiten, hoe geografische computertechnieken onze kennis over Romeinse wegenbouw verrijken, hoe de Neolatijnse studies ons o.a. verrassen met literaire creaties in genres als het epos en de science fiction, hoe receptiegeschiedenis vandaag de vinger legt op eeuwenlang gebruik van de klassieken ter promotie van een eurocentrisch wereldbeeld en tegelijk een nieuw, ruimer perspectief biedt.
De rubriek 'Onbekend, onbemind' promoot teksten die niet tot de typische schoolcanon behoren. Ook het artikel van Tom Ingelbrecht over de Narcissus van John Clapham sluit daarbij aan. In het luik 'Publieke stemmen' geven prominente deelnemers aan het cultureel-maatschappelijk debat mee hoe ze vandaag tegen de klassieken als discipline en als schoolvak aankijken. De klassieke talen en antieke culturen blijven duidelijk inspireren.
Koen Vandendriessche
DJDJD. Een pilootstudie van een vragenlijst over denken, weten en waarheid
€ 18,50
DJDJD is de afkorting van de Dacht Je Dat Je Dacht-vragenlijst, waarbij men uitgedaagd wordt om te
denken over denken. Mensen gaan er vaak vanuit dat ze goed denken en staan er niet bij stil dat ze denkfouten zouden maken. Velen beseffen zelfs niet dat je kan denken over denken!
DJDJD gaat niet zozeer over welke denkfouten je zelf maakt… als je dat al kan weten van jezelf. De lijst trekt met zijn 50 items vooral na hoe je denkt over denken. Met DJDJD kan je denkfouten leren erkennen en herkennen en leer je waarheid en vooral onwaarheid te vinden. Twijfelen mag! Er is zelfs een twijfelanalyse beschikbaar.
DJDJD verwijst natuurlijk naar het boek Dacht je dat je dacht? van Jos Peeters, maar het is niet noodzakelijk het bij de hand te nemen, al kan dat wel helpen. In DJDJD worden trouwens ook zaken aangesneden die niet in het boek staan.
Via een beperkte pilootstudie werd de lijst onderzocht zodat ieder ook zijn score kan vergelijken. DJDJD is voor ieder denkend mens geschikt! Het boek is er niet alleen voor diagnostisch aangelegde psychologen en filosofen maar is nuttig voor scholieren in het middelbaar onderwijs tot academici van allerlei slag en van krantenlezers en journalisten tot psychotherapeuten.
'DJDJD' en 'Dacht je dat je dacht' zijn ook als set te koop.
Jos Peeters, Leuven, is diagnostisch, therapeutisch en gerechtelijk psycholoog. Hij werkte jarenlang in het Jongerencentrum Cidar, een diagnostisch centrumin het jongerenwelzijn. Hij geraakte meer en meer gefascineerd door de wereld van denken, weten en waarheid. In 2016 verscheen van hem het boek Dacht je dat je dacht? (Garant).
DJDJD gaat niet zozeer over welke denkfouten je zelf maakt… als je dat al kan weten van jezelf. De lijst trekt met zijn 50 items vooral na hoe je denkt over denken. Met DJDJD kan je denkfouten leren erkennen en herkennen en leer je waarheid en vooral onwaarheid te vinden. Twijfelen mag! Er is zelfs een twijfelanalyse beschikbaar.
DJDJD verwijst natuurlijk naar het boek Dacht je dat je dacht? van Jos Peeters, maar het is niet noodzakelijk het bij de hand te nemen, al kan dat wel helpen. In DJDJD worden trouwens ook zaken aangesneden die niet in het boek staan.
Via een beperkte pilootstudie werd de lijst onderzocht zodat ieder ook zijn score kan vergelijken. DJDJD is voor ieder denkend mens geschikt! Het boek is er niet alleen voor diagnostisch aangelegde psychologen en filosofen maar is nuttig voor scholieren in het middelbaar onderwijs tot academici van allerlei slag en van krantenlezers en journalisten tot psychotherapeuten.
'DJDJD' en 'Dacht je dat je dacht' zijn ook als set te koop.
Jos Peeters, Leuven, is diagnostisch, therapeutisch en gerechtelijk psycholoog. Hij werkte jarenlang in het Jongerencentrum Cidar, een diagnostisch centrumin het jongerenwelzijn. Hij geraakte meer en meer gefascineerd door de wereld van denken, weten en waarheid. In 2016 verscheen van hem het boek Dacht je dat je dacht? (Garant).
DJDJD. Een pilootstudie van een vragenlijst over denken, weten en waarheid
€ 18,50
DJDJD is de afkorting van de Dacht Je Dat Je Dacht-vragenlijst, waarbij men uitgedaagd wordt om te
denken over denken. Mensen gaan er vaak vanuit dat ze goed denken en staan er niet bij stil dat ze denkfouten zouden maken. Velen beseffen zelfs niet dat je kan denken over denken!
DJDJD gaat niet zozeer over welke denkfouten je zelf maakt… als je dat al kan weten van jezelf. De lijst trekt met zijn 50 items vooral na hoe je denkt over denken. Met DJDJD kan je denkfouten leren erkennen en herkennen en leer je waarheid en vooral onwaarheid te vinden. Twijfelen mag! Er is zelfs een twijfelanalyse beschikbaar.
DJDJD verwijst natuurlijk naar het boek Dacht je dat je dacht? van Jos Peeters, maar het is niet noodzakelijk het bij de hand te nemen, al kan dat wel helpen. In DJDJD worden trouwens ook zaken aangesneden die niet in het boek staan.
Via een beperkte pilootstudie werd de lijst onderzocht zodat ieder ook zijn score kan vergelijken. DJDJD is voor ieder denkend mens geschikt! Het boek is er niet alleen voor diagnostisch aangelegde psychologen en filosofen maar is nuttig voor scholieren in het middelbaar onderwijs tot academici van allerlei slag en van krantenlezers en journalisten tot psychotherapeuten.
'DJDJD' en 'Dacht je dat je dacht' zijn ook als set te koop.
Jos Peeters, Leuven, is diagnostisch, therapeutisch en gerechtelijk psycholoog. Hij werkte jarenlang in het Jongerencentrum Cidar, een diagnostisch centrumin het jongerenwelzijn. Hij geraakte meer en meer gefascineerd door de wereld van denken, weten en waarheid. In 2016 verscheen van hem het boek Dacht je dat je dacht? (Garant).
DJDJD gaat niet zozeer over welke denkfouten je zelf maakt… als je dat al kan weten van jezelf. De lijst trekt met zijn 50 items vooral na hoe je denkt over denken. Met DJDJD kan je denkfouten leren erkennen en herkennen en leer je waarheid en vooral onwaarheid te vinden. Twijfelen mag! Er is zelfs een twijfelanalyse beschikbaar.
DJDJD verwijst natuurlijk naar het boek Dacht je dat je dacht? van Jos Peeters, maar het is niet noodzakelijk het bij de hand te nemen, al kan dat wel helpen. In DJDJD worden trouwens ook zaken aangesneden die niet in het boek staan.
Via een beperkte pilootstudie werd de lijst onderzocht zodat ieder ook zijn score kan vergelijken. DJDJD is voor ieder denkend mens geschikt! Het boek is er niet alleen voor diagnostisch aangelegde psychologen en filosofen maar is nuttig voor scholieren in het middelbaar onderwijs tot academici van allerlei slag en van krantenlezers en journalisten tot psychotherapeuten.
'DJDJD' en 'Dacht je dat je dacht' zijn ook als set te koop.
Jos Peeters, Leuven, is diagnostisch, therapeutisch en gerechtelijk psycholoog. Hij werkte jarenlang in het Jongerencentrum Cidar, een diagnostisch centrumin het jongerenwelzijn. Hij geraakte meer en meer gefascineerd door de wereld van denken, weten en waarheid. In 2016 verscheen van hem het boek Dacht je dat je dacht? (Garant).
Wetboek overheidsopdrachten, Editie 2022
€ 45,00
Twee wetten en twee uitvoeringsbesluiten maken de essentie uit van het Belgische overheidsopdrachtenrecht:
• de wet van 17 juni 2016 inzake overheidsopdrachten;
• de wet van 17 juni 2013 betreffende de motivering, de informatie en de rechtsmiddelen inzake overheidsopdrachten, bepaalde opdrachten voor werken, leveringen en diensten en concessies;
• het koninklijk besluit van 18 april 2017 plaatsing overheidsopdrachten in de klassieke sectoren;
• het koninklijk besluit van 14 januari 2013 tot bepaling van de algemene uitvoeringsregels van de overheidsopdrachten.
Met voorliggende Maklu-wetboekpocket worden deze wetten en koninklijke besluiten, in een gecoördineerde versie, voor een vlotte consultatie ter beschikking gesteld van al diegenen die dagdagelijks, in welke functie ook, bij het overheidsopdrachtengebeuren betrokken zijn.
De teksten werden bijgehouden tot en met het Belgisch Staatsblad van 3 januari 2022 en bevatten de nieuwe Europese aanbestedingsdrempels van toepassing voor de jaren 2022 en 2023.
• de wet van 17 juni 2016 inzake overheidsopdrachten;
• de wet van 17 juni 2013 betreffende de motivering, de informatie en de rechtsmiddelen inzake overheidsopdrachten, bepaalde opdrachten voor werken, leveringen en diensten en concessies;
• het koninklijk besluit van 18 april 2017 plaatsing overheidsopdrachten in de klassieke sectoren;
• het koninklijk besluit van 14 januari 2013 tot bepaling van de algemene uitvoeringsregels van de overheidsopdrachten.
Met voorliggende Maklu-wetboekpocket worden deze wetten en koninklijke besluiten, in een gecoördineerde versie, voor een vlotte consultatie ter beschikking gesteld van al diegenen die dagdagelijks, in welke functie ook, bij het overheidsopdrachtengebeuren betrokken zijn.
De teksten werden bijgehouden tot en met het Belgisch Staatsblad van 3 januari 2022 en bevatten de nieuwe Europese aanbestedingsdrempels van toepassing voor de jaren 2022 en 2023.
Wetboek overheidsopdrachten, Editie 2022
€ 45,00
Twee wetten en twee uitvoeringsbesluiten maken de essentie uit van het Belgische overheidsopdrachtenrecht:
• de wet van 17 juni 2016 inzake overheidsopdrachten;
• de wet van 17 juni 2013 betreffende de motivering, de informatie en de rechtsmiddelen inzake overheidsopdrachten, bepaalde opdrachten voor werken, leveringen en diensten en concessies;
• het koninklijk besluit van 18 april 2017 plaatsing overheidsopdrachten in de klassieke sectoren;
• het koninklijk besluit van 14 januari 2013 tot bepaling van de algemene uitvoeringsregels van de overheidsopdrachten.
Met voorliggende Maklu-wetboekpocket worden deze wetten en koninklijke besluiten, in een gecoördineerde versie, voor een vlotte consultatie ter beschikking gesteld van al diegenen die dagdagelijks, in welke functie ook, bij het overheidsopdrachtengebeuren betrokken zijn.
De teksten werden bijgehouden tot en met het Belgisch Staatsblad van 3 januari 2022 en bevatten de nieuwe Europese aanbestedingsdrempels van toepassing voor de jaren 2022 en 2023.
• de wet van 17 juni 2016 inzake overheidsopdrachten;
• de wet van 17 juni 2013 betreffende de motivering, de informatie en de rechtsmiddelen inzake overheidsopdrachten, bepaalde opdrachten voor werken, leveringen en diensten en concessies;
• het koninklijk besluit van 18 april 2017 plaatsing overheidsopdrachten in de klassieke sectoren;
• het koninklijk besluit van 14 januari 2013 tot bepaling van de algemene uitvoeringsregels van de overheidsopdrachten.
Met voorliggende Maklu-wetboekpocket worden deze wetten en koninklijke besluiten, in een gecoördineerde versie, voor een vlotte consultatie ter beschikking gesteld van al diegenen die dagdagelijks, in welke functie ook, bij het overheidsopdrachtengebeuren betrokken zijn.
De teksten werden bijgehouden tot en met het Belgisch Staatsblad van 3 januari 2022 en bevatten de nieuwe Europese aanbestedingsdrempels van toepassing voor de jaren 2022 en 2023.
Hoop in filosofisch perspectief – Filosofie & Praktijk jg 42 nr. 3 (2021)
€ 15,00
Dit derde nummer van F&P in de jaargang 42 is een themanummer, gewijd aan de betekenis van hoop en wordt gevuld door de bijdragen aan het symposium Hoop in filosofisch perspectief georganiseerd door de Vereniging van Ethici in Nederland (VvEN). Het symposium vond plaats op vrijdag 1 oktober 2021 in Utrecht, en aldaar presenteerden Roel Kuiper, Claudia Blöser, Willem Lemmens en Justine van Lawick hun lezingen over hoop.
De verschillende bijdragen aan het symposium worden ingeleid door Heleen Torringa, bestuurslid van de VvEN, in haar introductie “Thema Hoop, of: Waarom je van filosofie kunt houden” en een ander VvEN-bestuurslid, Eric Boot, verzorgt een uitgebreide invulling van de rubriek Minima Philosophica met “Een apologie voor het coronatoegangsbewijs”, tevens relevant voor andere coronamaatregelen.
Alvorens dit nummer van F&P wordt besloten door de gebruikelijke rubriek “Signalementen” is er nóg een bijdrage van een VvEN-bestuurslid, een boekbespreking “De benen van rabbi Hillel”, een bespreking van De getemde mens. Waar komt (volgens u) onze moraal vandaan?, onder redactie van Martin Harlaar. De bespreking is meer precies van de hand van een voormalig bestuurslid van de VvEN, tevens voormalig redactielid van F&P: Patrick Delaere. Op 2 november j.l. overleed Patrick na een kort en hevig ziekbed op 67-jarige leeftijd. De redactie zal zijn inbreng met zekerheid missen, maar wenst eerst en vooral de familie van Patrick veel sterkte toe met dit verlies dat een voortijdig eind aan veel plannen betekent. Graag verwijst de redactie naar het In Memoriam in dit nummer van F&P, gewijd aan deze Homo viator of “wegaflegger, levenswandelaar, passant”.
De verschillende bijdragen aan het symposium worden ingeleid door Heleen Torringa, bestuurslid van de VvEN, in haar introductie “Thema Hoop, of: Waarom je van filosofie kunt houden” en een ander VvEN-bestuurslid, Eric Boot, verzorgt een uitgebreide invulling van de rubriek Minima Philosophica met “Een apologie voor het coronatoegangsbewijs”, tevens relevant voor andere coronamaatregelen.
Alvorens dit nummer van F&P wordt besloten door de gebruikelijke rubriek “Signalementen” is er nóg een bijdrage van een VvEN-bestuurslid, een boekbespreking “De benen van rabbi Hillel”, een bespreking van De getemde mens. Waar komt (volgens u) onze moraal vandaan?, onder redactie van Martin Harlaar. De bespreking is meer precies van de hand van een voormalig bestuurslid van de VvEN, tevens voormalig redactielid van F&P: Patrick Delaere. Op 2 november j.l. overleed Patrick na een kort en hevig ziekbed op 67-jarige leeftijd. De redactie zal zijn inbreng met zekerheid missen, maar wenst eerst en vooral de familie van Patrick veel sterkte toe met dit verlies dat een voortijdig eind aan veel plannen betekent. Graag verwijst de redactie naar het In Memoriam in dit nummer van F&P, gewijd aan deze Homo viator of “wegaflegger, levenswandelaar, passant”.
Hoop in filosofisch perspectief – Filosofie & Praktijk jg 42 nr. 3 (2021)
€ 15,00
Dit derde nummer van F&P in de jaargang 42 is een themanummer, gewijd aan de betekenis van hoop en wordt gevuld door de bijdragen aan het symposium Hoop in filosofisch perspectief georganiseerd door de Vereniging van Ethici in Nederland (VvEN). Het symposium vond plaats op vrijdag 1 oktober 2021 in Utrecht, en aldaar presenteerden Roel Kuiper, Claudia Blöser, Willem Lemmens en Justine van Lawick hun lezingen over hoop.
De verschillende bijdragen aan het symposium worden ingeleid door Heleen Torringa, bestuurslid van de VvEN, in haar introductie “Thema Hoop, of: Waarom je van filosofie kunt houden” en een ander VvEN-bestuurslid, Eric Boot, verzorgt een uitgebreide invulling van de rubriek Minima Philosophica met “Een apologie voor het coronatoegangsbewijs”, tevens relevant voor andere coronamaatregelen.
Alvorens dit nummer van F&P wordt besloten door de gebruikelijke rubriek “Signalementen” is er nóg een bijdrage van een VvEN-bestuurslid, een boekbespreking “De benen van rabbi Hillel”, een bespreking van De getemde mens. Waar komt (volgens u) onze moraal vandaan?, onder redactie van Martin Harlaar. De bespreking is meer precies van de hand van een voormalig bestuurslid van de VvEN, tevens voormalig redactielid van F&P: Patrick Delaere. Op 2 november j.l. overleed Patrick na een kort en hevig ziekbed op 67-jarige leeftijd. De redactie zal zijn inbreng met zekerheid missen, maar wenst eerst en vooral de familie van Patrick veel sterkte toe met dit verlies dat een voortijdig eind aan veel plannen betekent. Graag verwijst de redactie naar het In Memoriam in dit nummer van F&P, gewijd aan deze Homo viator of “wegaflegger, levenswandelaar, passant”.
De verschillende bijdragen aan het symposium worden ingeleid door Heleen Torringa, bestuurslid van de VvEN, in haar introductie “Thema Hoop, of: Waarom je van filosofie kunt houden” en een ander VvEN-bestuurslid, Eric Boot, verzorgt een uitgebreide invulling van de rubriek Minima Philosophica met “Een apologie voor het coronatoegangsbewijs”, tevens relevant voor andere coronamaatregelen.
Alvorens dit nummer van F&P wordt besloten door de gebruikelijke rubriek “Signalementen” is er nóg een bijdrage van een VvEN-bestuurslid, een boekbespreking “De benen van rabbi Hillel”, een bespreking van De getemde mens. Waar komt (volgens u) onze moraal vandaan?, onder redactie van Martin Harlaar. De bespreking is meer precies van de hand van een voormalig bestuurslid van de VvEN, tevens voormalig redactielid van F&P: Patrick Delaere. Op 2 november j.l. overleed Patrick na een kort en hevig ziekbed op 67-jarige leeftijd. De redactie zal zijn inbreng met zekerheid missen, maar wenst eerst en vooral de familie van Patrick veel sterkte toe met dit verlies dat een voortijdig eind aan veel plannen betekent. Graag verwijst de redactie naar het In Memoriam in dit nummer van F&P, gewijd aan deze Homo viator of “wegaflegger, levenswandelaar, passant”.
De Belgische Grondwet / La Constitution belge, Editie/Édition 2022
€ 32,50
Sedert 1831 is de Belgische Grondwet — naast diverse herzieningen met een meer beperkte draagwijdte — het voorwerp geweest van acht grote herzieningen. De eerste twee grondwetsherzieningen, deze van 1893 en 1921, betroffen de democratisering van het kiesstelsel. De zes daaropvolgende herzieningen, deze van 1970, 1980, 1988-1989, 1993, 2001 en 2012-2014, vormden het unitaire België om tot een federale Staat.
Sinds de publicatie van de Gecoördineerde Grondwet van 17 februari 1994 (BS 17 februari 1994) werden in de Grondwet diverse nieuwe artikelen ingevoegd, in een belangrijk aantal artikelen wijzigingen doorgevoerd en een aantal artikelen opgeheven. In voorliggende tweetalige editie 2022 van de Gecoördineerde Grondwet zijn al deze wijzigingen en toevoegingen in de tekst van de Grondwet geïncorporeerd (stand van zaken Belgisch Staatsblad 3 januari 2022).
Depuis 1831, la Constitution belge - en plus de diverses révisions de portée plus limitée - a fait l’objet de huit révisions majeures. Les deux premières révisions constitutionnelles, celles de 1893 et 1921, concernaient la démocratisation du système électoral. Les six révisions ultérieures, celles de 1970, 1980, 1988-1989, 1993, 2001 et 2012-2014, ont transformé la Belgique unitaire en un État fédéral.
Depuis la publication de la Constitution coordonnée du 17 février 1994 (MB 17 février 1994), divers nouveaux articles ont été insérés dans la Constitution, des modifications ont été apportées à un nombre important d’articles et un certain nombre d’articles ont été supprimés. Dans cette édition bilingue 2022 de la Constitution coordonnée, toutes ces modifications ont été incorporées dans le texte de la Constitution (texte mis à jour jusqu’au Moniteur belge du 3 janvier 2022).
Constant De Koninck (ed./éd.)
Ere-eerste auditeur bij het Rekenhof
Premier auditeur honoraire à la Cour des comptes
Sinds de publicatie van de Gecoördineerde Grondwet van 17 februari 1994 (BS 17 februari 1994) werden in de Grondwet diverse nieuwe artikelen ingevoegd, in een belangrijk aantal artikelen wijzigingen doorgevoerd en een aantal artikelen opgeheven. In voorliggende tweetalige editie 2022 van de Gecoördineerde Grondwet zijn al deze wijzigingen en toevoegingen in de tekst van de Grondwet geïncorporeerd (stand van zaken Belgisch Staatsblad 3 januari 2022).
Depuis 1831, la Constitution belge - en plus de diverses révisions de portée plus limitée - a fait l’objet de huit révisions majeures. Les deux premières révisions constitutionnelles, celles de 1893 et 1921, concernaient la démocratisation du système électoral. Les six révisions ultérieures, celles de 1970, 1980, 1988-1989, 1993, 2001 et 2012-2014, ont transformé la Belgique unitaire en un État fédéral.
Depuis la publication de la Constitution coordonnée du 17 février 1994 (MB 17 février 1994), divers nouveaux articles ont été insérés dans la Constitution, des modifications ont été apportées à un nombre important d’articles et un certain nombre d’articles ont été supprimés. Dans cette édition bilingue 2022 de la Constitution coordonnée, toutes ces modifications ont été incorporées dans le texte de la Constitution (texte mis à jour jusqu’au Moniteur belge du 3 janvier 2022).
Constant De Koninck (ed./éd.)
Ere-eerste auditeur bij het Rekenhof
Premier auditeur honoraire à la Cour des comptes
De Belgische Grondwet / La Constitution belge, Editie/Édition 2022
€ 32,50
Sedert 1831 is de Belgische Grondwet — naast diverse herzieningen met een meer beperkte draagwijdte — het voorwerp geweest van acht grote herzieningen. De eerste twee grondwetsherzieningen, deze van 1893 en 1921, betroffen de democratisering van het kiesstelsel. De zes daaropvolgende herzieningen, deze van 1970, 1980, 1988-1989, 1993, 2001 en 2012-2014, vormden het unitaire België om tot een federale Staat.
Sinds de publicatie van de Gecoördineerde Grondwet van 17 februari 1994 (BS 17 februari 1994) werden in de Grondwet diverse nieuwe artikelen ingevoegd, in een belangrijk aantal artikelen wijzigingen doorgevoerd en een aantal artikelen opgeheven. In voorliggende tweetalige editie 2022 van de Gecoördineerde Grondwet zijn al deze wijzigingen en toevoegingen in de tekst van de Grondwet geïncorporeerd (stand van zaken Belgisch Staatsblad 3 januari 2022).
Depuis 1831, la Constitution belge - en plus de diverses révisions de portée plus limitée - a fait l’objet de huit révisions majeures. Les deux premières révisions constitutionnelles, celles de 1893 et 1921, concernaient la démocratisation du système électoral. Les six révisions ultérieures, celles de 1970, 1980, 1988-1989, 1993, 2001 et 2012-2014, ont transformé la Belgique unitaire en un État fédéral.
Depuis la publication de la Constitution coordonnée du 17 février 1994 (MB 17 février 1994), divers nouveaux articles ont été insérés dans la Constitution, des modifications ont été apportées à un nombre important d’articles et un certain nombre d’articles ont été supprimés. Dans cette édition bilingue 2022 de la Constitution coordonnée, toutes ces modifications ont été incorporées dans le texte de la Constitution (texte mis à jour jusqu’au Moniteur belge du 3 janvier 2022).
Constant De Koninck (ed./éd.)
Ere-eerste auditeur bij het Rekenhof
Premier auditeur honoraire à la Cour des comptes
Sinds de publicatie van de Gecoördineerde Grondwet van 17 februari 1994 (BS 17 februari 1994) werden in de Grondwet diverse nieuwe artikelen ingevoegd, in een belangrijk aantal artikelen wijzigingen doorgevoerd en een aantal artikelen opgeheven. In voorliggende tweetalige editie 2022 van de Gecoördineerde Grondwet zijn al deze wijzigingen en toevoegingen in de tekst van de Grondwet geïncorporeerd (stand van zaken Belgisch Staatsblad 3 januari 2022).
Depuis 1831, la Constitution belge - en plus de diverses révisions de portée plus limitée - a fait l’objet de huit révisions majeures. Les deux premières révisions constitutionnelles, celles de 1893 et 1921, concernaient la démocratisation du système électoral. Les six révisions ultérieures, celles de 1970, 1980, 1988-1989, 1993, 2001 et 2012-2014, ont transformé la Belgique unitaire en un État fédéral.
Depuis la publication de la Constitution coordonnée du 17 février 1994 (MB 17 février 1994), divers nouveaux articles ont été insérés dans la Constitution, des modifications ont été apportées à un nombre important d’articles et un certain nombre d’articles ont été supprimés. Dans cette édition bilingue 2022 de la Constitution coordonnée, toutes ces modifications ont été incorporées dans le texte de la Constitution (texte mis à jour jusqu’au Moniteur belge du 3 janvier 2022).
Constant De Koninck (ed./éd.)
Ere-eerste auditeur bij het Rekenhof
Premier auditeur honoraire à la Cour des comptes